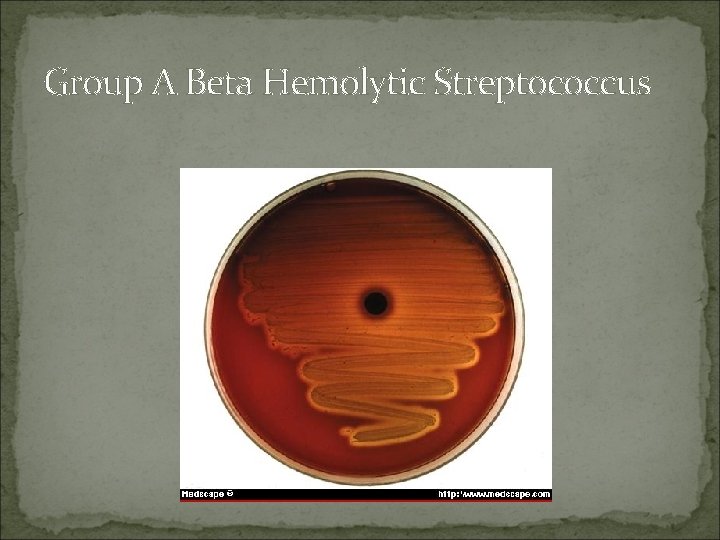
Group A Beta Hemolytic Streptococcus

Pharyngitis PHARYNGITIS What is it Inflammation of the

- Slides: 58
Pharyngitis
PHARYNGITIS What is it? Inflammation of the Pharynx secondary to an infectious agent Most common infectious agents are Group A Streptococcus and various viral agents Often co-exists with tonsillitis
Etiology Strep. A Rhinovirus Mycoplasma Coronavirus Strep. G Adenovirus Strep. C CMV Corynebacterium EBV diphteriae Toxoplasmosis Gonorrhea Tularemia HSV Enterovirus HIV
Epidemiology of Streptococcal Pharyngitis Spread by contact with respiratory secretions Peaks in winter and spring School age child (5 -15 y) Communicability highest during acute infection Patient no longer contagious after 24 hours of antibiotics If hospitalized, droplet precautions needed until no longer contagious
PHARYNGITIS Classic symptoms → Fever, throat pain, dysphagia Ø VIRAL → Most likely concurrent URI symptoms of rhinorrhea, cough, hoarseness, conjunctivitis & ulcerative lesions Ø Fever and throat pain are usually acute in onset
PHARYNGITIS Physical Exam VIRAL Ø EBV – White exudate covering erythematous pharynx and tonsils, cervical adenopathy, Ø Adenovirus/Coxsackie – vesicles/ulcerative lesions present on pharynx or posterior soft palate Ø Also look for conjunctivitis
PHARYNGITIS Physical Exam Bacterial Ø GAS – look for whitish exudate covering pharynx and tonsils tender anterior cervical adenopathy palatal/uvular petechiae scarlatiniform rash covering torso and upper arms Ø Spread via respiratory particle droplets – NO school attendance until 24 hours after initiation of appropriate antibiotic therapy Absence of viral symptoms (rhinorrhea, cough, hoarseness)
Scarlatiniform Rash
Pharyngeal exudates: Strep. pyogenes C. diphtheriae EBV
Infectious Mononucleosis
Skin rash: S. pyogenes HIV EBV
Conjunctivitis: Adenovirus
Suppurative Complications of Group A Streptococcal Pharyngitis Otitis media Sinusitis Peritonsillar and retropharyngeal abscesses Suppurative cervical adenitis
Bilateral peritonsillar abscesses
Streptococcal Cervical Adenitis
Nonsuppurative Complications of Group A Streptococcus Acute rheumatic fever follows only streptococcal pharyngitis (not group A strep skin infections) Acute glomerulonephritis May follow pharyngitis or skin infection (pyoderma) Nephritogenic strains
PHARYNGITIS
PHARYNGITIS
pharyngitis
Clinical manifestation (Strep. ) Rapid onset. . Erythma Headache Exudates GI Symptoms Palatine petechiae Sore throat Enlarged tonsils Anterior cervical adenopathy &Tender Red& swollen uvula
Clinical manifestation (Viral) Gradual onset Rhinorrhea Cough Diarrhea Fever
Diagnosis of streptococcal pharyngitis
Ø Rapid strep antigen → detects GAS antigen Ø Tonsillar swab → 3 -5 minutes to perform • 95% specificity, 90 -93% sensitivity Ø GAS Throat culture → “gold standard” • >95% sensitivity
Differential diagnosis Retropharyngeal abscesses Peritonsilar abscesses Ludwig angina Epiglotitis Thrush Autoimmune ulceration Kawasaki
Prevention and control of GAβHS pharyngitis Primary prevention: A) Reducing overall exposure to GAS. 1) Improving living standards. 2) Adequate nutrition. 3) Provision of easily accessible laboratory facilities for diagnosis of GAβHS. 4) Pasteurization of milk and exclude of infected people from handling food. 5) Health education to public and health workers about modes of transmission and the relationship of streptococcal sore throat to ARF/RHD.
B) Immunization: Although there have been multiple attempts to produce a GAβHS vaccine for approximately a century, none of the candidate vaccines has proceeded beyond preliminary animal or human studies until recently.
Secondary prevention A- Treatment of GAβHS pharyngitis: The gold standard of therapy for GAβHS is penicillin. Treatment of GAβHS pharyngitis should, 1) Relieve the symptoms of the acute illness. 2) Eliminate transmissibility. 3) Prevent both suppurative and nonsupporative sequelae.
→ Do so to prevent ARF (Acute Rheumatic Fever) Ø GAS → ü Oral PCN – treatment of choice ü 10 day course of therapy or ü Single dose of IM Benzathine PCN G – 1. 2 million units x 1 ü Azithromycin, Clindamycin, or 1 st generation cephalosporins for PCN allergy
Carrier of strep: Clindamycin , Amoxicillin clavulanic Retropharyngeal abscesses: Drainage + Antibiotics Peritonsilar abscesses: penicillin + Aspiration
B) Primary prophylaxis of RF: This refers to the prevention of ARF by timely and complete antibiotic treatment of symptomatic GAβHS pharyngitis. C)Surgical approach pharyngitis: to recurrent GAβHS More clearly defined indicators for surgical intervention include patients with peritonsillar abscess or severe obstructive symptoms.
Tertiary prevention This refers to measures to reduce the severity or long-term impact of GAS diseases. In practice, it mainly refers to management of patients with RF/ RHD.
What symptomatic treatment could you offer the patient? Acetaminophen gargling with warm salt water throat lozenges fluids, warm or cold, can be soothing
Treatment Ø VIRAL – Supportive care only – Analgesics, Antipyretics, Fluids Ø No strong evidence supporting use of oral or intramuscular corticosteroids for pain relief → few studies show transient relief within first 12– 24 hrs after administration Ø EBV – infectious mononucleosis Ø activity restrictions – mortality in these pts most commonly associated with abdominal trauma and splenic rupture
Recurrent pharyngitis Etiology: Nonpenicillin treatment , Different strain , Another cause pharyngitis Treatment: Tonsilectomy if Culture positive, severe GABHS more than 7 times during previous year or 5 times each year during two previous year
Antibiotic started immediately with symptomatic pharyngitis and positive Rapid test (Without culture) 1 -Clinical diagnosis of scarlet fever 2 -Household contact with documented strep. Pharyngitis 3 -Past history of ARF 4 -Recent history of ARF in a family member
Strawberry Tongue in Scarlet Fever
Rash of Scarlet Fever
Group A Streptococcus
Group A Beta Hemolytic Streptococcus
Candida in a man with AIDS
Viral
Herpangina
Clinical Prediction Rule for Strep Throat Fever over 38 C Absence of cough Tender ant. cervical adenopathy Tonsillar swelling or exudate Age< 15 y Age> 45 Mc. Isaac modification of the Centor Criteria (added age) 1 1 1 -1
Probability of Strep throat based on points (pretest probability) -1 to 0 1 2 3 4 or 5 1% low probability 10% 17% intermediate probability 35% 51% high probability
3 categories low probability of GABHS - no test, no treat (< 10%) intermediate probability - test (10%<x< 51%) high probability - treat, no test ( 50% <)
Case 1 A 30 year old man comes to your office with a scratchy throat and a headache for one day. His nose is slightly stuffy and he has a non-productive cough. He denies allergies and fever. He smokes 1 ppd. VS : T= 37. 1 PE: ears - TM's normal nose – clear mucus and boggy mucosa face - no sinus tenderness neck - tender adenopathy
Case 1 mild erythema left tonsillar exudate present
How many points does our patient have? Fever over 38 C Absence of cough Tender ant. cervical adenopathy Tonsillar swelling or exudate Age< 15 y Age> 45 Total = 2 Pretest probability= 17% 0 0 1 1 0 0
Rapid Strep Test Done Result is negative Symptomatic treatment
Case 2 A 6 year old girl is brought to your office with low grade fever, sore throat, and poor appetite for 3 days. Father states that she does not have cough or runny nose. No vomiting or diarrhea. She is allergic to Penicillin. PE : T = 38. 2 P 110 ears - TM's normal nose - clear throat - tonsils - beefy red and almost touching in midline. Uvula in midline, no exudate, no petechiae neck - enlarged tender anterior cervical nodes lungs – clear skin - sandpaper rash prominent around axilla
Case 2
Case 3 A 19 year old woman comes to your office with 2 days of sore throat, cough, and runny nose. Patient feels feverish but has not taken her temperature. She has no other symptoms and no history of other medical problems. The patient very much wants penicillin. T = 37. 4 P 80 ears - TM's normal nose - boggy red mucosa with clear mucus neck - shotty nodes lungs - clear
Case 3
How many points does our patient have? Fever over 38 C Absence of cough Tender ant. cervical adenopathy Tonsillar swelling or exudate Age< 15 y Age> 45 Total = 0 Pretest probability= 1% 0 0 0
What do you do? No test No treat – no antibiotics Treat symptoms